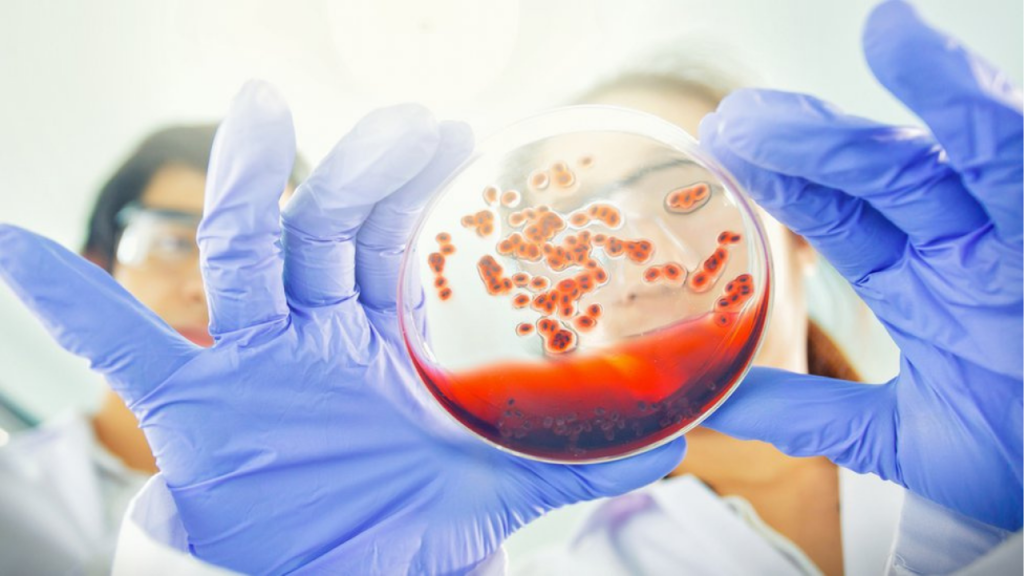
The Cancer That Was Not Human: the medical case that challenged biology 3 cancer - cancer

In 2015, physicians reported in The New England Journal of Medicine an extraordinary case: a man with HIV developed tumors caused not by his own cells, but by cancerous cells from a tapeworm. The finding changed the understanding of the relationship between infection, immunity, and cancer.
An unprecedented cancer documented by the NEJM

The patient was a 41-year-old man living in Colombia who presented with advanced HIV and severe immunosuppression. He sought medical care for weight loss, fatigue, and persistent respiratory symptoms. Imaging studies revealed multiple tumors in the lungs, liver, and lymph nodes, a pattern typical of metastatic cancer.
Initially, physicians assumed it was a conventional human cancer. However, biopsies revealed something unusual: the tumor cells were much smaller than expected and did not fully match any known type of cancer.
Faced with this anomaly, the medical team turned to advanced genetic and molecular analysis techniques. The results were surprising. The DNA of the malignant cells did not match the patient’s. Instead, it corresponded to Hymenolepis nana, a dwarf tapeworm common in regions with poor sanitation.
The study concluded that the parasite had undergone a process of malignant transformation inside the host’s body. The tapeworm’s cancerous cells multiplied and spread, behaving in a manner similar to aggressive human cancer. This was the first documented case of cancer derived directly from a parasite in a human being.
The role of the immune system and HIV

Researchers emphasized that this phenomenon was only possible due to the critical state of the patient’s immune system. In healthy individuals, foreign cells—including parasitic ones—are usually detected and eliminated quickly by the body’s defenses.
In this case, HIV had drastically reduced CD4 lymphocyte levels, weakening the body’s ability to control infections. This lack of immune surveillance allowed the tapeworm’s cells to grow unchecked.
Although Hymenolepis nana is a relatively common and generally mild infection, physicians stressed that it does not cause cancer under normal conditions. The malignant transformation observed resulted from an exceptional combination of factors: chronic parasitic infection, profound immunosuppression, and absence of an effective defensive response.
The parasite’s cells, despite being ten times smaller than human cells, showed clear characteristics of malignancy, such as uncontrolled growth and tissue invasion. The case reinforced the importance of the immune system as a key barrier against unusual cancer processes.
Medical and public health implications
The NEJM article notes that this finding has significant clinical implications, especially in regions where HIV and parasitic infections are common. The authors warn that similar cases could go unnoticed or be misdiagnosed as conventional human Cancers.
From a medical standpoint, the case expands the traditional definition of Cancer, showing that it does not always arise from a person’s own cells. It also highlights the value of genetic testing when clinical findings do not fit standard diagnoses.
In public health terms, the study reinforces the need to improve control of parasitic infections, ensure early access to antiretroviral therapy, and provide close medical follow-up for immunocompromised patients. This is not a risk for the general population, but an extremely rare phenomenon associated with very specific conditions.
Researchers emphasize that this case does not imply that tapeworms routinely “transmit Cancer.” Rather, it represents a biological exception that helps clarify the boundaries between infection, immunity, and oncology.
The case described by The New England Journal of Medicine shows that cancer can arise in unexpected ways when the body’s defenses fail. Although extraordinarily rare, this finding expands medical knowledge and underscores the importance of immunity in protection against complex diseases.
Reference:
- The New England Journal of Medicine / Malignant Transformation of Hymenolepis nana in a Human Host. Link
COMPARTE ESTE ARTICULO EN TUS REDES FAVORITAS:
Relacionado
Esta entrada también está disponible en:
Español
Discover more from Cerebro Digital
Subscribe to get the latest posts sent to your email.








